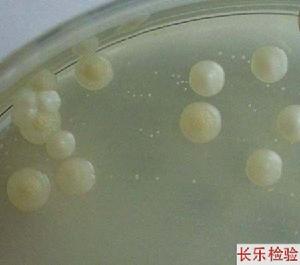
熱瘡病

熱瘡病
熱瘡病唐容川所著 《熱瘡病》 對熱瘡病進行了較為系統的闡述,並多有創見。主要學術觀點有:1.水、氣、血、火關係。重點闡述了“水即化氣”、“火即化血”的觀點。2.注重脾胃而發乎脾陰。無論在對氣血、水火的論述中,還是在對血證的治療中,都強調了脾胃的重要作用。在注重脾胃的基礎上,唐氏還補東垣之未備,提出滋養脾陰。3.首創治血四法,止血、消瘀、寧血、補虛,四者乃通治血證之大綱。4.血證治法宜忌,禁汗、禁吐、適下、宜和。
臨床表現
五心煩熱,頭暈耳鳴,腰膝酸軟,骨蒸潮熱,兩顴潮紅,口乾舌燥,盜汗遺精,舌紅少苔
病理機制
熱瘡病
熱瘡病熱瘡病重點闡述了“水即化氣”、“火即化血”的觀點。他認為:“蓋人身之氣,生於臍下丹田氣海之中。臍下者,腎與膀胱,水所歸宿之地也。此水不自化為氣,又賴鼻間吸入天陽,從肺管引心火下入臍之下蒸其水,使化為氣。”“五臟六腑息以相吹,止此一氣而已。”天陽蒸化腎水而化為氣,氣之所生則為鼓動五臟六腑的生理機能之動力,並且各臟腑之間的聯繫也都依靠氣來維繫。氣隨太陽經脈布護於外,是為衛氣,氣上交於肺而司呼吸,故氣與水本屬一家。然氣生於水又能蒸化水,水隨氣而化,則外達肌表氣化為汗,下走膀胱氣化為溲,上輸於肺氣化生津,如霧露之溉而濡澤周身。氣之與水生理相依則必病理相及,若水病停滯則影響到氣化,津液不生,無以輸布,五臟失榮;若氣病不能外達肌表則無作汗;氣病不能升降,則水停聚飲為癃、為腫、為瀉,不一而足。故臨床“治氣即為治水,治水即是治氣”。以人參補氣立能生津,小柴胡湯和胃氣亦能通津液,清燥救肺湯生津液以補肺氣,豬苓湯利水而助氣化,都氣丸補水以益腎氣等實例來示以後人氣水同治的大法,“此治水之邪,即以治氣,與滋水之陰,即以補氣者,並行而不悖也。”
治療藥方
1.熱盛津傷重,加蘆根、石斛、銀花。
2.熱津氣傷,背微惡寒,加人參。
3.肺熱壅盛,加杏仁、姜皮、銀花、魚腥草等。
